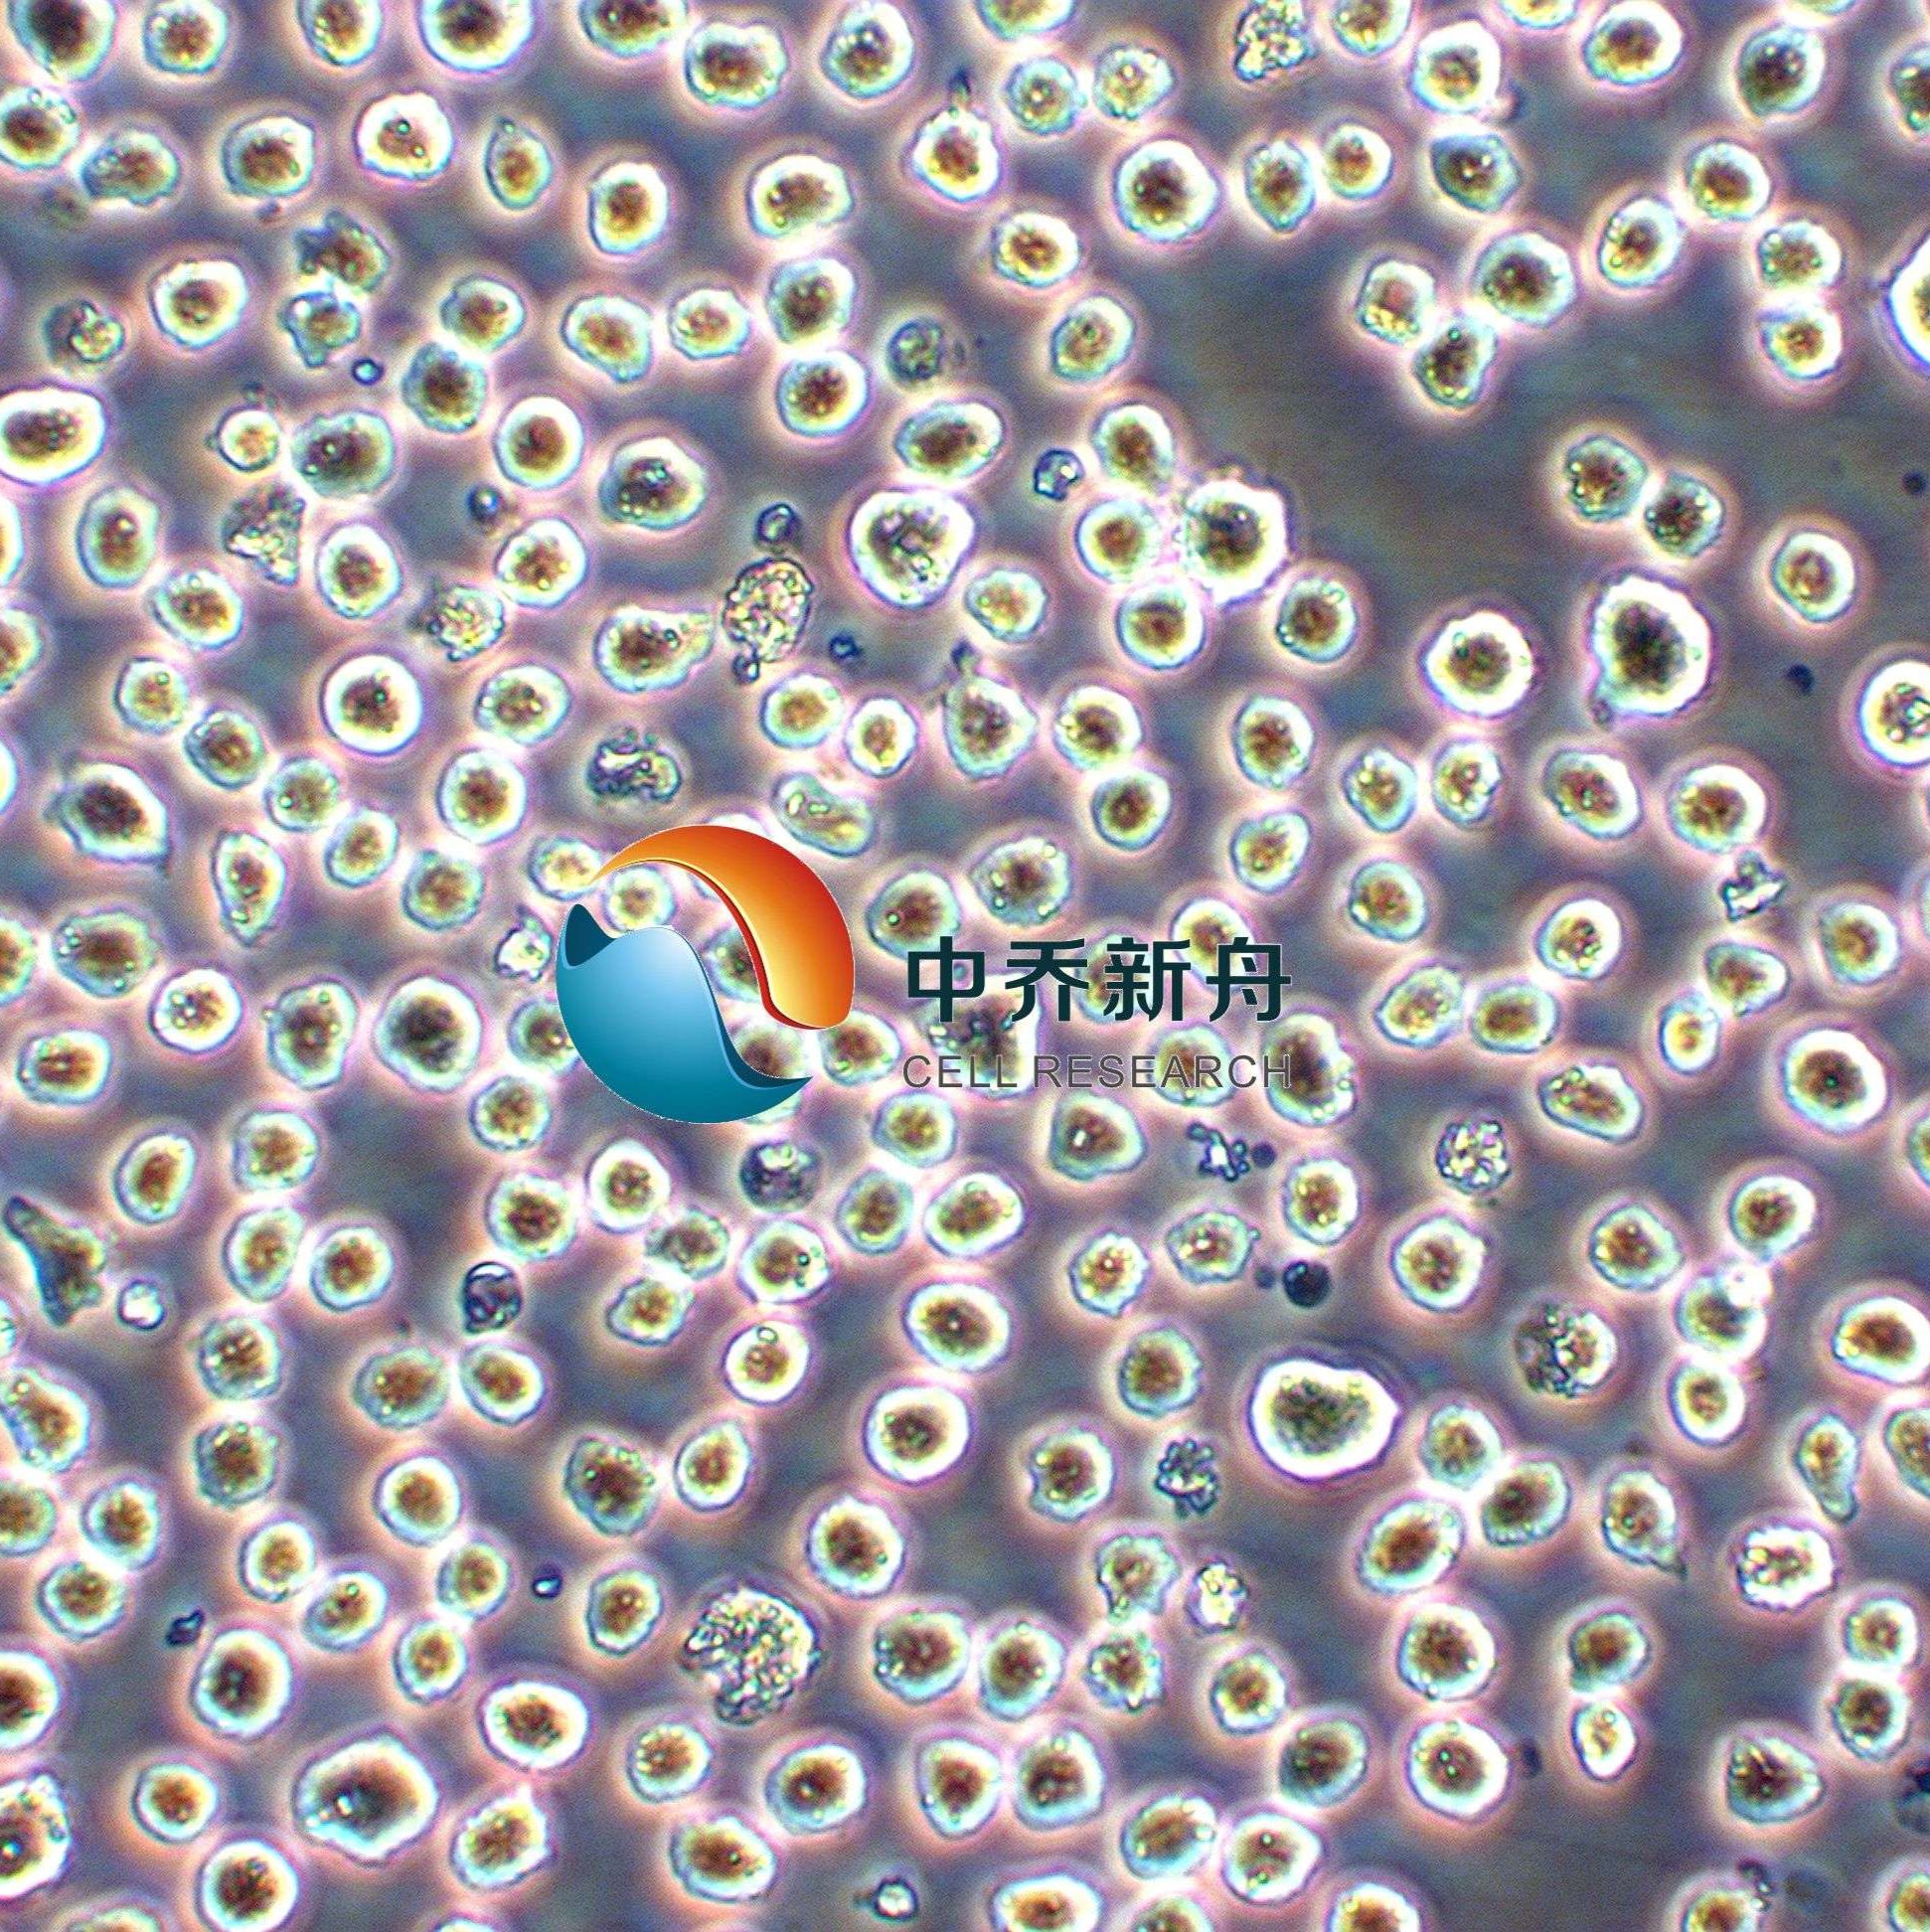
Karpas-299人间变性大细胞淋巴瘤细胞株

相关产品推荐更多 >
万千商家帮你免费找货
0 人在求购买到急需产品
- 详细信息
- 文献和实验
- 技术资料
- 英文名:
Karpas-299
- 库存:
100
- 供应商:
中乔新舟
- 品系:
细胞系
- 运输方式:
常温
- 年限:
液氮长期
- 生长状态:
悬浮生长
- 规格:
T25
|
产品名称 |
Karpas-299人间变性大细胞淋巴瘤细胞株 |
|
货号 |
ZQ0718 |
|
产品介绍 |
Karpas-299是一种人间变性大细胞淋巴瘤细胞株,最初在1986年从一名25岁患有T细胞非霍奇金淋巴瘤的男性患者的外周血中分离得到。这种细胞系后来被归类为CD30阳性的间变性大细胞淋巴瘤(ALCL),其特征是携带NPM-ALK融合基因,是一种ALK阳性的细胞系。Karpas-299细胞系广泛用于淋巴瘤的研究,特别是在间变性大细胞淋巴瘤的研究中。它们可用于研究肿瘤细胞的生物学行为、药物筛选、免疫学研究以及探索ALCL的分子机制。 |
|
种属 |
人 |
|
性别/年龄 |
男/25岁 |
|
组织 |
淋巴瘤 |
|
疾病 |
人类非霍奇金Ki阳性大细胞淋巴瘤 |
|
细胞类型 |
肿瘤细胞 |
|
形态学 |
淋巴母细胞 |
|
生长方式 |
悬浮 |
|
倍增时间 |
26 hours (PubMed=20922763); ~30 hours (ECACC=06072604) |
|
培养基和添加剂 |
RPMI-1640(品牌:中乔新舟 货号:ZQ-200)+20%胎牛血清(中乔新舟 货号:ZQ0500)+1%P/S(中乔新舟 货号:CSP006) |
|
推荐完全培养基货号 |
ZQ-218 |
|
生物安全等级 |
BSL-1 |
|
培养条件 |
95%空气,5%二氧化碳;37℃ |
|
STR位点信息 |
Amelogenin: X,Y |
|
抗原表达/受体表达 |
*** |
|
基因表达 |
*** |
|
保藏机构 |
ECACC; 06072604 |
|
供应限制 |
仅供科研使用 |
上海中乔新舟生物科技有限公司成立于2011年,历经十多年发展,主要专注于细胞生物学产品的研究和开发,专注于为药企、各类科研机构及CRO企业提供符合标准规范的细胞培养服务、细胞培养基、细胞检测试剂盒、细胞培养试剂,胎牛血清和细胞生物学技术服务等。
公司一直致力于为高等院校、研究机构、医院、CRO及CDMO企业提供细胞培养完整解决方案,这些产品旨在满足细胞培养的多样需求,确保实验和研究的有效进行。引用中乔新舟(ZQXZBIO)产品和服务的文献超数千篇。

产品服务
细胞资源:原代细胞、细胞株、干细胞、示踪细胞、耐药株细胞、永生化细胞等基因工程细胞。
试剂产品:胎牛血清、完全培养基(适用于原代细胞及细胞株)、无血清培养基、基础培养基、细胞转染试剂、重组因子、胰酶和双抗等等细胞培养所有实验相关产品。
技术服务:稳转株构建、原代细胞分离、特殊培养基定制服务、细胞检测等。

目前产品已经畅销国内30多个省市,与客户建立长期的合作伙伴关系,共同实现成功。全体员工将不懈努力,继续为科研人员提供优良的产品和服务,致力成为全球细胞培养领域的参与者。

企业愿景
致力于成为国内细胞培养基产业的佼佼者,生物医药领域上游原材料的优良提供商。
企业使命
成长为专业细胞系及原代细胞培养供应商、专业细胞培养基及培养试剂生产商。
企业荣誉


风险提示:丁香通仅作为第三方平台,为商家信息发布提供平台空间。用户咨询产品时请注意保护个人信息及财产安全,合理判断,谨慎选购商品,商家和用户对交易行为负责。对于医疗器械类产品,请先查证核实企业经营资质和医疗器械产品注册证情况。
文献和实验
PubMed=1565469
Bodner S.M., Minna J.D., Jensen S.M., D'Amico D., Carbone D.P., Mitsudomi T., Fedorko J., Buchhagen D.L., Nau M.M., Gazdar A.F., Linnoila R.I.
Expression of mutant p53 proteins in lung cancer correlates with the class of p53 gene mutation.
Oncogene 7:743-749(1992)
在上呼吸道病毒感染后发病,有些病人发病前有用某些药物如抗菌素的病史。过去曾认为本病是T细胞调节障碍引起的B细胞过度增生。近年来的研究发现,在很多病人是T细胞淋巴瘤。基因重组研究证实为单克隆性T细胞增生。目前认为本病可能是免疫系统功能障碍引起的克隆性淋巴细胞增生,在此基础上出现恶性 细胞株 大量增生,发展成为恶性淋巴瘤。 本病预后差别很大。约半数病人不经任何治疗可生存2~4年,约25%用激素治疗或并用其他化疗药物可缓解。有些病变为进行性,可发展为恶性淋巴瘤,预后不佳
素的病史。过去曾认为本病是T细胞调节障碍引起的B细胞过度增生。近年来的研究发现,在很多病人是T细胞淋巴瘤。基因重组研究证实为单克隆性T细胞增生。目前认为本病可能是免疫系统功能障碍引起的克隆性淋巴细胞增生,在此基础上出现恶性 细胞株 大量增生,发展成为恶性淋巴瘤。 本病预后差别很大。约半数病人不经任何治疗可生存2~4年,约25%用激素治疗或并用其他化疗药物可缓解。有些病变为进行性,可发展为恶性淋巴瘤,预后不佳。到晚期由于免疫功能低下,多数病人死于继发
中不同组织的所有细胞中,染色体的带型是相同的。 Base pair(bp) 碱基对,在DNA双螺旋中腺嘌呤[A]与胸腺嘧啶[T],或胞嘧啶[C]与鸟嘌呤[G]配对。 bax bcl-2基因家族的一个成员,是在凋亡的调节中的重要部分。bax与bcl-2--起形成一氨基二聚体,阻断bcl-2的抗凋亡活性。 bcl-2 一种细胞基因,其蛋白质产物[Bcl-2]抑制凋亡。它是滤泡性B细胞淋巴瘤的癌基因,染色体易位t[18;14
技术资料暂无技术资料 索取技术资料